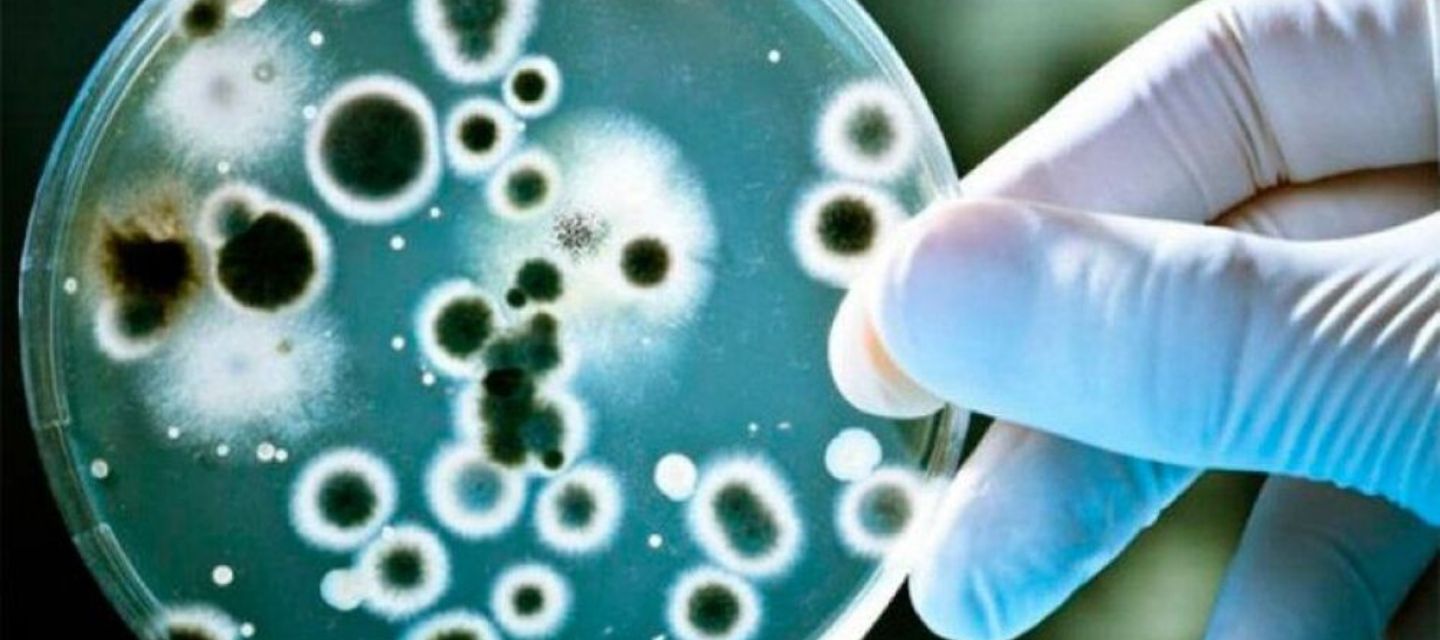
El mal uso de los antibióticos impulsa bacterias que ya no responden a los tratamientos.

El mal uso de los antibióticos impulsa bacterias que ya no responden a los tratamientos. Expertos alertan sobre su expansión y la urgencia de políticas sanitarias.
El aumento de bacterias que resisten casi todos los antibióticos preocupa a la comunidad médica mundial. Expertos advierten que el mal uso de estos fármacos y la falta de incentivos para crear nuevos medicamentos agravan la crisis sanitaria.
Otras noticias: Trump quiere internar a personas sin hogar con enfermedades mentales, mientras recorta los programas que las apoyan
Según la microbióloga Virginia Villegas, bacterias como Escherichia coli, Klebsiella pneumoniae, Pseudomonas aeruginosa y Staphylococcus aureus son responsables de múltiples infecciones graves en hospitales de Latinoamérica. Estas bacterias, conocidas como “superresistentes”, causan desde infecciones urinarias hasta neumonías severas. Además, muchas pueden vivir en el intestino o la piel del paciente y atacar cuando el sistema inmunológico está debilitado.
Léase también:'Varones Unidos', el grupo que lidera el uruguayo acusado de doble femicidio en Argentina
Villegas señala que el 30% de las infecciones hospitalarias proviene de bacterias que los propios pacientes portan, mientras otro 30% se debe a deficiencias en el lavado de manos o limpieza de los centros médicos. “La resistencia bacteriana se ha diseminado en todo el mundo, pero la situación en Latinoamérica es alarmante”, afirmó la investigadora del Grupo de Resistencia Bacteriana de la Universidad del Bosque.
El desarrollo de nuevos antibióticos es lento y costoso, lo que reduce el interés de las farmacéuticas. Por ello, los expertos piden a los Gobiernos crear planes de contención y políticas de higiene hospitalaria más estrictas. El grupo de Villegas asesora hospitales en toda América Latina y alerta sobre bacterias peligrosas como la Klebsiella pneumoniae, resistente a casi todos los fármacos. “Estamos ante una evolución natural de las bacterias, pero también ante una falta de acción humana”, concluyó la especialista.
Te puede interesar: Huracán Melissa devasta la histórica ciudad portuaria de Black River en Jamaica










